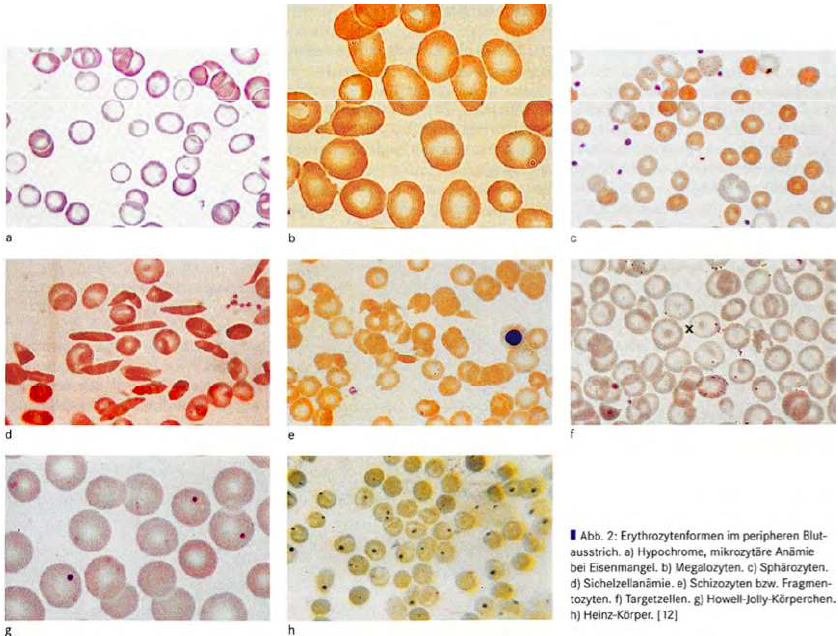

Mikrositik anemi
Mikrositik anemi, çok küçük kırmızı kan hücreleri (mikrositler) ile karakterize bir anemidir. Genellikle belirgin veya gizli kan kaybından kaynaklanan bir demir eksikliğini gösterir. Nadir nedenler, doğal ladin gibi ince bağırsak hastalıklarıdır.

Nedenleri
Kural olarak, mikrositik anemi, demir eksikliğine dayanır. Oksijen bağlayıcı bileşeni (hem) demir gerektiren kırmızı kan pigmenti hemoglobinin işlev bozukluğundan kaynaklanır. Kanama bozukluğu nedeniyle oluşan eritrositler sadece çok küçük olmakla kalmaz, aynı zamanda çok az hemoglobin içerirler ve bu da kan yaymasına indirgenmiş bir renk olarak yansır (hipokromi, hipokromazi). Bu nedenle bir mikrositik anemi genellikle aynı zamanda bir hipokromik anemidir (“mikrositik hipokromik anemi”).
Belirtiler
Semptomlar, kandaki oksijen taşıyıcılarının eksikliğinden kaynaklanan vücuttaki göreceli oksijen eksikliği ile karakterize edilir. Odak noktası – aneminin şiddetine bağlı olarak – kolay yorgunluk, halsizlik, erken bitkinlik, hafif eforla veya zaten istirahat halindeyken nefes darlığı, baş dönmesi ve gözlerin önünde titremedir. Koroner arter hastalığı (koroner yetmezlik, koroner arterlerin daralması) olan kişilerde anemiden dolayı kalp ağrısı (angina pektoris) gelişebilir.
Teşhis
- Mikrositik anemide, kan sayımı çok düşük sayıda kırmızı kan hücresi gösterir (eritrosit eksikliği). Kırmızı kan hücreleri de çok küçüktür (düşük MCV, mikrositler) ve çok az hemoglobin içerir (azalmış MCH, azalmış MCHC). Genel olarak, bu düşük bir hematokrite (Hct) yol açar.
- Kan sayımında mikrositer anemi saptanırsa, tanı genellikle kanama kaynağı aranarak başlar.
- Belirgin bir kanama bulunmazsa (örneğin yaralanma, aşırı adet kanaması (hipermenore)), bir yandan çok hassas olan ve zaten diş etlerinin kanamasını düşündüren dışkıda gizli kan testi (FOBT, dışkıda gizli kan testi) takip eder, Öte yandan, kanamanın tüm olası nedenlerini her zaman kanıtlamaz, böylece kişi yanlış bir güvenlik duygusuna kapılabilir. Gastrointestinal sistem endoskopisi yaşlılarda ve muhtemelen genç insanlarda kesinlikle düşünülmelidir.
- Kalın bağırsakta hemorajik inflamasyon (kolit), polipler ve kolon kanseri dışlanmalıdır.
- Gastrointestinal sistemin üst kısmında, neden mide mukozasının kanlı bir iltihabı (hemorajik gastrit) veya mide veya duodenumda bir ülser (mide ülseri, duodenum ülseri) olabilir. Koroner arter daralması vakalarında kanı inceltmek için anti-romatizmal ilaçlar veya ASA kullanırken bu nadir değildir.
- Kanama kaynağı saptanamazsa, ince bağırsak hastalığından kaynaklanan demir emilim bozukluğu düşünülmelidir. Oldukça nadir görülen bu hastalıklardan çölyak (yerli ladin) göz önünde bulundurulur. Teşhisi için duodenumdan mukoza zarı örneği (duodenumdan biyopsi) ve anti-endomisyal antikorların veya transglutaminazlara karşı antikorların tespiti ile gastroskopi kullanılır.
Terapi
Mikrositer anemi tedavisi, nedene bağlıdır. Demir eksikliği durumunda kanamanın kaynağı belirlenmeli ve tedavi edilmelidir. Bir demir emilim bozukluğu durumunda, enjeksiyon veya infüzyon yoluyla parenteral demir temini gerekli olacaktır. Vücudun zamanla aşırı demir yüklenmesi olmamasına özen gösterilmelidir.